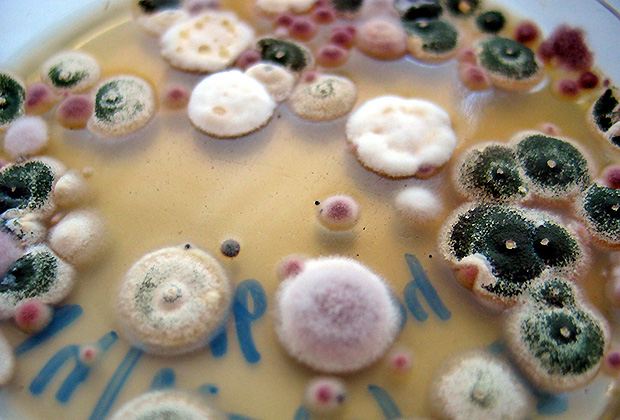

Von den Menschen fast unbemerkt leisten Pilze im Boden den Bäumen und anderen Pflanzen wertvolle Dienste. Wissenschaftler von der Forschungsanstalt Agroscope haben den «Basar im Boden» untersucht.
Das unterirdische Ökosystem vergleichen die Forschenden um Marcel van der Heijden von Agroscope mit einem Basar, wie es in einer Mitteilung vom Bundesamt für Umwelt (BAFU) vom Donnerstag heisst: «Im Angebot stehen Produkte und Dienstleistungen.» Als potenzielle Käufer suchen Bäume, Kräuter und Gräser mit ihren Wurzeln nach Nährstoffen wie Stickstoff und Phosphor.
Perfektes "Tauschgeschäft"
Wichtigster Handelspartner sind die Pilze. «Diese reichen mit ihren feinen Fäden in die kleinsten Bodenporen und gelangen dort an Nährstoffe, die für Pflanzenwurzeln unzugänglich sind», erklären die Wissenschaftler. Bezahlen lassen sich die Pilze demnach mit Zucker, den sie selber nicht herstellen können. Ein perfektes Tauschgeschäft. Es wird ermöglicht, weil die Pilze an die Wurzeln andocken und sie mit einem dichten Fadengeflecht umhüllen. 80 Prozent aller Landpflanzen gehen eine solche Symbiose mit Pilzen ein. Dies wird als Mykorrhiza (verpilzte Wurzel) bezeichnet.
In der Schweiz wurden bisher rund 2000 Mykorrhiza-Pilze nachgewiesen, darunter bekannte Speisepilze wie Steinpilz und Eierschwamm. «Interessanterweise treiben die Wurzelpilze auch Handel mit jungen Bäumen, die nur wenig Zucker ausscheiden, aber Kunden von morgen sind», heisst es weiter.
Wertvolle Dienstleister für Landwirte
Die Rolle der Pilze ist nicht zu unterschätzen. So konnte Van der Heijden zeigen, dass Pflanzen in natürlichen Ökosystemen einen Grossteil des Phosphors und Stickstoffs über das Netzwerk erhalten. Viele Pflanzen verbinden sich gleichzeitig mit mehreren Pilzen, wie die Forscher schreiben. Dank der Bodenpilze und anderer Organismen wie Regenwürmer könnten auch Landwirte deutlich höhere Maisernten einfahren.
Neben Produkten handeln die Wurzelpilze auch mit Dienstleistungen, wie es weiter heisst. Der Pilzmantel schütze etwa die Wurzeln wie ein Filter vor Krankheitserregern und Schadstoffen. Ausserdem verbessere er die Wasseraufnahme und mache seine Partner widerstandsfähiger gegen Trockenheit.
Reduzieren Lachgas-Ausstoss
Auch für den Gewässerschutz leisten die Pilze einen Beitrag: Sie halten mit anderen Bodenorganismen fast 50 Kilogramm Stickstoff pro Hektare zurück. Ohne diese Lebewesen würde der Stickstoff in das Grundwasser oder nahegelegene Bäche gelangen und dort zu unerwünscht hohen Nitratgehalten führen, wie die Forscher schreiben.
Experimente, die im Rahmen eines vom Nationalfonds finanzierten Projekts durchgeführt wurden, ergaben, dass die Pilze auch den Ausstoss von Lachgas, einem hochpotenten Treibhausgas, aus dem Boden um über ein Drittel reduzieren können.
Pilze auf dem Rückmarsch
Der Mensch belohnt die Arbeit der Pilze aber nicht immer gut, wie die Forscher beklagen. Überdüngung, zu häufige Bodenbearbeitung, Pestizide und stickstoffhaltige Schadstoffe, die über die Luft in die Böden gelangen, können die Bodenorganismen schädigen. Die Pilze seien bereits auf dem Rückmarsch, was sich negativ auf Ernteerträge und die oberirdische Artenvielfalt auswirken könne.
Die UNO-Generalversammlung hat das Jahr 2015 zum Internationalen Jahr des Bodens erklärt. Um die Bedeutung der Bodenlebewesen für den Menschen sichtbar zu machen, stellen das BAFU und das Nationale Forschungsprogramm «Ressource Boden» jeden Monat einen Organismus vor.